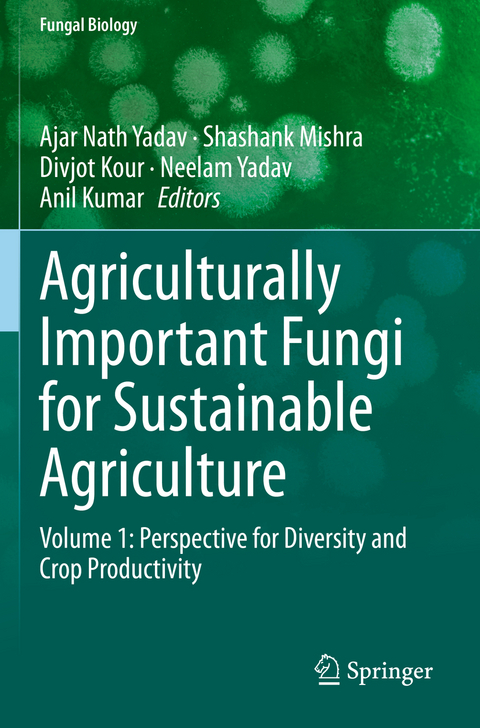
Agriculturally Important Fungi for Sustainable Agriculture -

Agriculturally Important Fungi for Sustainable Agriculture
Springer International Publishing (Verlag)
978-3-030-45973-4 (ISBN)
Microbes are ubiquitous in nature. Among microbes, fungal communities play an important role in agriculture, the environment, and medicine. Vast fungal diversity has been associated with plant systems, namely epiphytic fungi, endophytic fungi, and rhizospheric fungi.
These fungi associated with plant systems play an important role in plant growth, crop yield, and soil health. Rhizospheric fungi, present in rhizospheric zones, get their nutrients from root exudates released by plant root systems, which help with their growth, development, and microbe activity. Endophytic fungi typically enter plant hosts through naturally occurring wounds that are the result of plant growth, through root hairs, or at epidermal conjunctions. Phyllospheric fungi may survive or proliferate on leaves depending on material influences in leaf diffuseness or exudates.
The diverse nature of these fungal communities is a key component of soil-plant systems, where they are engaged in anetwork of interactions endophytically, phyllospherically, as well as in the rhizosphere, and thus have emerged as a promising tool for sustainable agriculture. These fungal communities promote plant growth directly and indirectly by using plant growth promoting (PGP) attributes. These PGP fungi can be used as biofertilizers and biocontrol agents in place of chemical fertilizers and pesticides for a more eco-friendly method of promoting sustainable agriculture and environments.
This first volume of a two-volume set covers the biodiversity of plant-associated fungal communities and their role in plant growth promotion, the mitigation of abiotic stress, and soil fertility for sustainable agriculture. This book should be useful to those working in the biological sciences, especially for microbiologists, microbial biotechnologists, biochemists, and researchers and scientists of fungal biotechnology.
lt;p>Ajar Nath Yadav is an Assistant Professor (Sr. Scale) in Department of Biotechnology, Dr. Khem Singh Gill Akal College of Agriculture, Eternal University, Baru Sahib, Himachal Pradesh, India. He has 4 years of teaching and 10 year of research experiences in the field of Microbial Biotechnology, Microbial Diversity, and Plant-Microbe-Interactions. Dr. Yadav obtained doctorate degree in Microbial Biotechnology, jointly from IARI, New Delhi and BIT, Mesra, Ranchi, India; M.Sc. (Biotechnology) from Bundelkhand University and B.Sc. (CBZ) from University of Allahabad, India. Dr. Yadav has 136 publications, which include 69 research/review papers, 11 books, 54 book chapters, and 02 patents with h-index of 27, i10-index of 64, and 2287 citations (Google Scholar). Dr. Yadav has published 111 research communications in different international and national conferences. Dr. Yadav has got 12 Best Paper Presentation Awards, and 01 Young Scientist Award (NASI-Swarna Jyanti Purskar). Dr. Yadav received "Outstanding Teacher Award" in 6th Annual Convocation 2018 by Eternal University, Baru Sahib, Himachal Pradesh. He has been serving as an editor/editorial board member and reviewer for more than 35 national and international peer-reviewed journals. He has lifetime membership of Association of Microbiologist in India, and Indian Science Congress Council, India.
Shashank Mishra is presently working as Scientist 'C', Biotech Park, Lucknow, Uttar Pradesh, India. He obtained his doctorate degree in Science "Industrial Biotechnology" in 2015, from Birla Institute of Technology, Mesra, Ranchi, India; M.Phil. (Biotechnology) in 2008 from Alagappa University, Tamil Nadu; M.Sc. (Botany), in 2005 from Dr. R.M.L. University, Ayodhya; M.Sc. (Biotechnology), in 2004 from Barkatullah University, Bhopal and B.Sc. (Botany and Chemistry) in 2001 from Dr. R.M.L. University, Ayodhya, India. He has made pioneering contributions in the area of Microbial Biotechnology; Natural product synthesis and Environmental Microbiology for food, pharmaceutical and Human Health. In his credit 21 Publications [06 research papers, 02 review articles, 03 books and 10 book chapters] in different reputed international and national journals and publishers with 82 Citation, h-index-05 and i10-index 04 (Google Scholar). He has reported first time with high concentration of phenolic compounds by optimizing various parameters and published in peer-reviewed and referred international journals. He has published 16 abstracts in different conferences/symposiums/workshops. He has presented 16 papers presentation [12 poster + 04 oral] in conferences/symposiums and got 01 best poster presentations Award, Dr. Mishra has contributed in organizing 07 conference/workshops. He has deposited 03 nucleotide sequences to NCBI GenBank databases: in public domain. He is reviewer in 06 international journals including BMC Microbiology, Indian Phytopathology, PLOS One, Scientific Reports and Archive of Phytopathology and Plant Protection and 3 Biotech. He has the lifetime membership of Association of microbiologist of India (AMI) and Vigyan Bharti (VIBHA).
Divjot Kour is currently working as Project Assistant in DEST funded project "Development of Microbial Consortium as Bio-inoculants for Drought and Low Temperature Growing Crops for Organic Farming in Himachal Pradesh". Dr. Kour obtained doctorate degree in Microbial Biotechnology from Department of Biotechnology, Dr. Khem Singh Gill Akal College of Agriculture, Eternal University, Baru Sahib, Himachal Pradesh, India. She obtained M.Phil. in Microbiology in 2017 from Shoolini University of Biotechnology and Management Sciences, Solan, Himachal Pradesh; M.Sc. in Microbiology from University of Jammu, Jammu and Kashmir in 2015 and B.Sc. from University of Jammu, Jammu and Kashmir in 2014. She has research experience of 04 years. In her credit 39 publications (11 rese
Agriculturally Important Fungi: Plant - Microbe Association for Mutual Benefits.- Endophytic Fungi: Diversity, Abundance, and Plant Growth Promoting Attributes.- The Role of Arbuscular Mycorrhizal Fungal Community in Paddy Soil.- Natural Arbuscular Mycorrhizal Colonization of Wheat and Maize Crops under different Agricultural Practices.- Arbuscular Mycorrhizal Fungi, and their Potential Applications for Sustainable Agriculture.- Phosphate Solubilizing Fungi: Current Perspective, Mechanisms and Potential Agricultural Applications.- Fungal Phytohormones: Plant Growth-Regulating Substances and their Applications in Crop Productivity.- Phytohormones Producing Fungal Communities: Metabolic Engineering for Abiotic Stress Tolerance in Crops.- Fungal Biofertilizers for Sustainable Agricultural Productivity.- Role of Algae-Fungi relationship in Sustainable Agriculture.- Fungi as a Biological Tool for Sustainable Agriculture.- AgriculturallyImportant Fungi for Crop Productivity: Current Research and Future Challenges.
| Erscheinungsdatum | 27.06.2021 |
|---|---|
| Reihe/Serie | Fungal Biology |
| Zusatzinfo | XVII, 300 p. 33 illus., 22 illus. in color. |
| Verlagsort | Cham |
| Sprache | englisch |
| Maße | 155 x 235 mm |
| Gewicht | 489 g |
| Themenwelt | Naturwissenschaften ► Biologie ► Genetik / Molekularbiologie |
| Naturwissenschaften ► Biologie ► Mikrobiologie / Immunologie | |
| Naturwissenschaften ► Biologie ► Mykologie | |
| Schlagworte | abiotic stress • biocontrol • Fungal Biotechnology • Plant growth promotion • sustainable agriculture • systematic botany |
| ISBN-10 | 3-030-45973-X / 303045973X |
| ISBN-13 | 978-3-030-45973-4 / 9783030459734 |
| Zustand | Neuware |
| Informationen gemäß Produktsicherheitsverordnung (GPSR) | |
| Haben Sie eine Frage zum Produkt? |
aus dem Bereich


